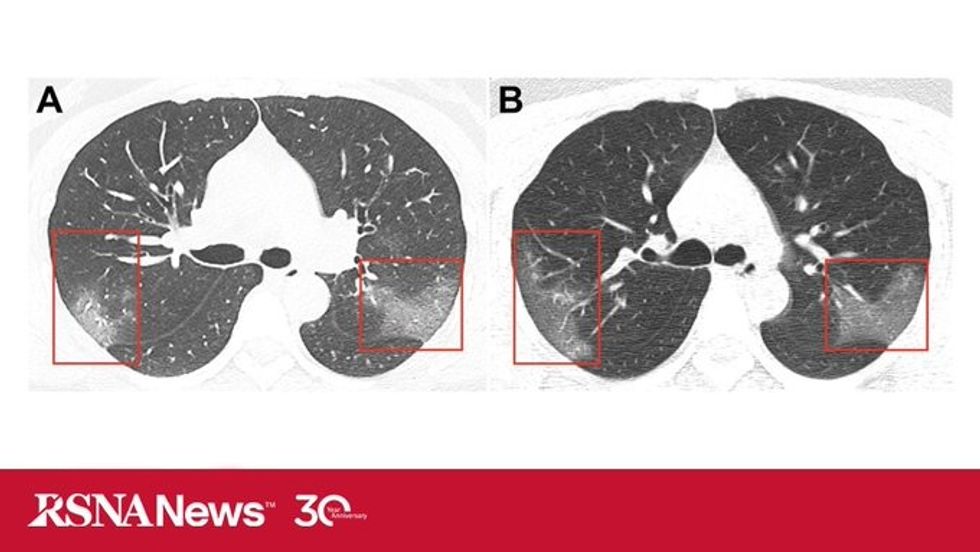
2 7

Mjekët tregojnë se çfarë u bënë mushkërive coronavirusi, rëntgenografia zbulon të dhëna shokuese – fillon me kollitje dhe temperaturë

Mjekët kanë publikuar imazhet e rëntgenografisë që tregojnë më së miri se çfarë u bënë mushkërive coronavirusi. Kur në spitalin Landzou u pranua një grua 33-vjeçe, kishte temperaturë të madhe, kollitje që i kishte zgjatur për më shumë se pesë ditë.
Frymëmarrjen e kishte shumë të vështirë dhe kishte shumë njolla të zeza nëpër trup, që janë shenja që vuan nga ndonjë virusi. Pacientja punon në qytetin kinez Wuhan, që konsiderohet si qendra e epidemisë, transmeton Telegrafi.
Në imazhe mjekët kanë hasur në hije të bardha të njohura si xhamat e qumështit, që paralajmërojnë se mushkëritë pjesërisht janë të mbushura me lëngje.
Imazhet janë publikuar në revistën shkencorë Radiology, kurse tekstin e kanë përpiluar ekipi i mjekëve të spitalit në Landzou. Ata pretendojnë se pacientët e infektuar me coronavirus, fillimisht vërejtën se kanë infeksione që mund të dëmtojnë mushkëritë dhe të shkaktojnë ndezjen e tyre që kërcënon jetën e njeriut.
Sipas tyre mushkëritë mbushen me lëngje, dhe për këtë arsye mjekët menjëherë u japin terapinë që u ndihmon në hapjen e kanaleve të frymëmarrjes.
Mjekët paralajmërojnë së në fillim shumë lehtë mund të ngatërrohet coronavirusi me ndezjen e mushkërive. Megjithatë imazhet e rëntgenografisë kanë treguar se pas tre ditëve gjendja e pacientit përkeqësohet siç ka ndodhur në raste me SARS dhe MERS, viruse këto gjithashtu që kishin shpërthyer në Kinë. /Telegrafi/